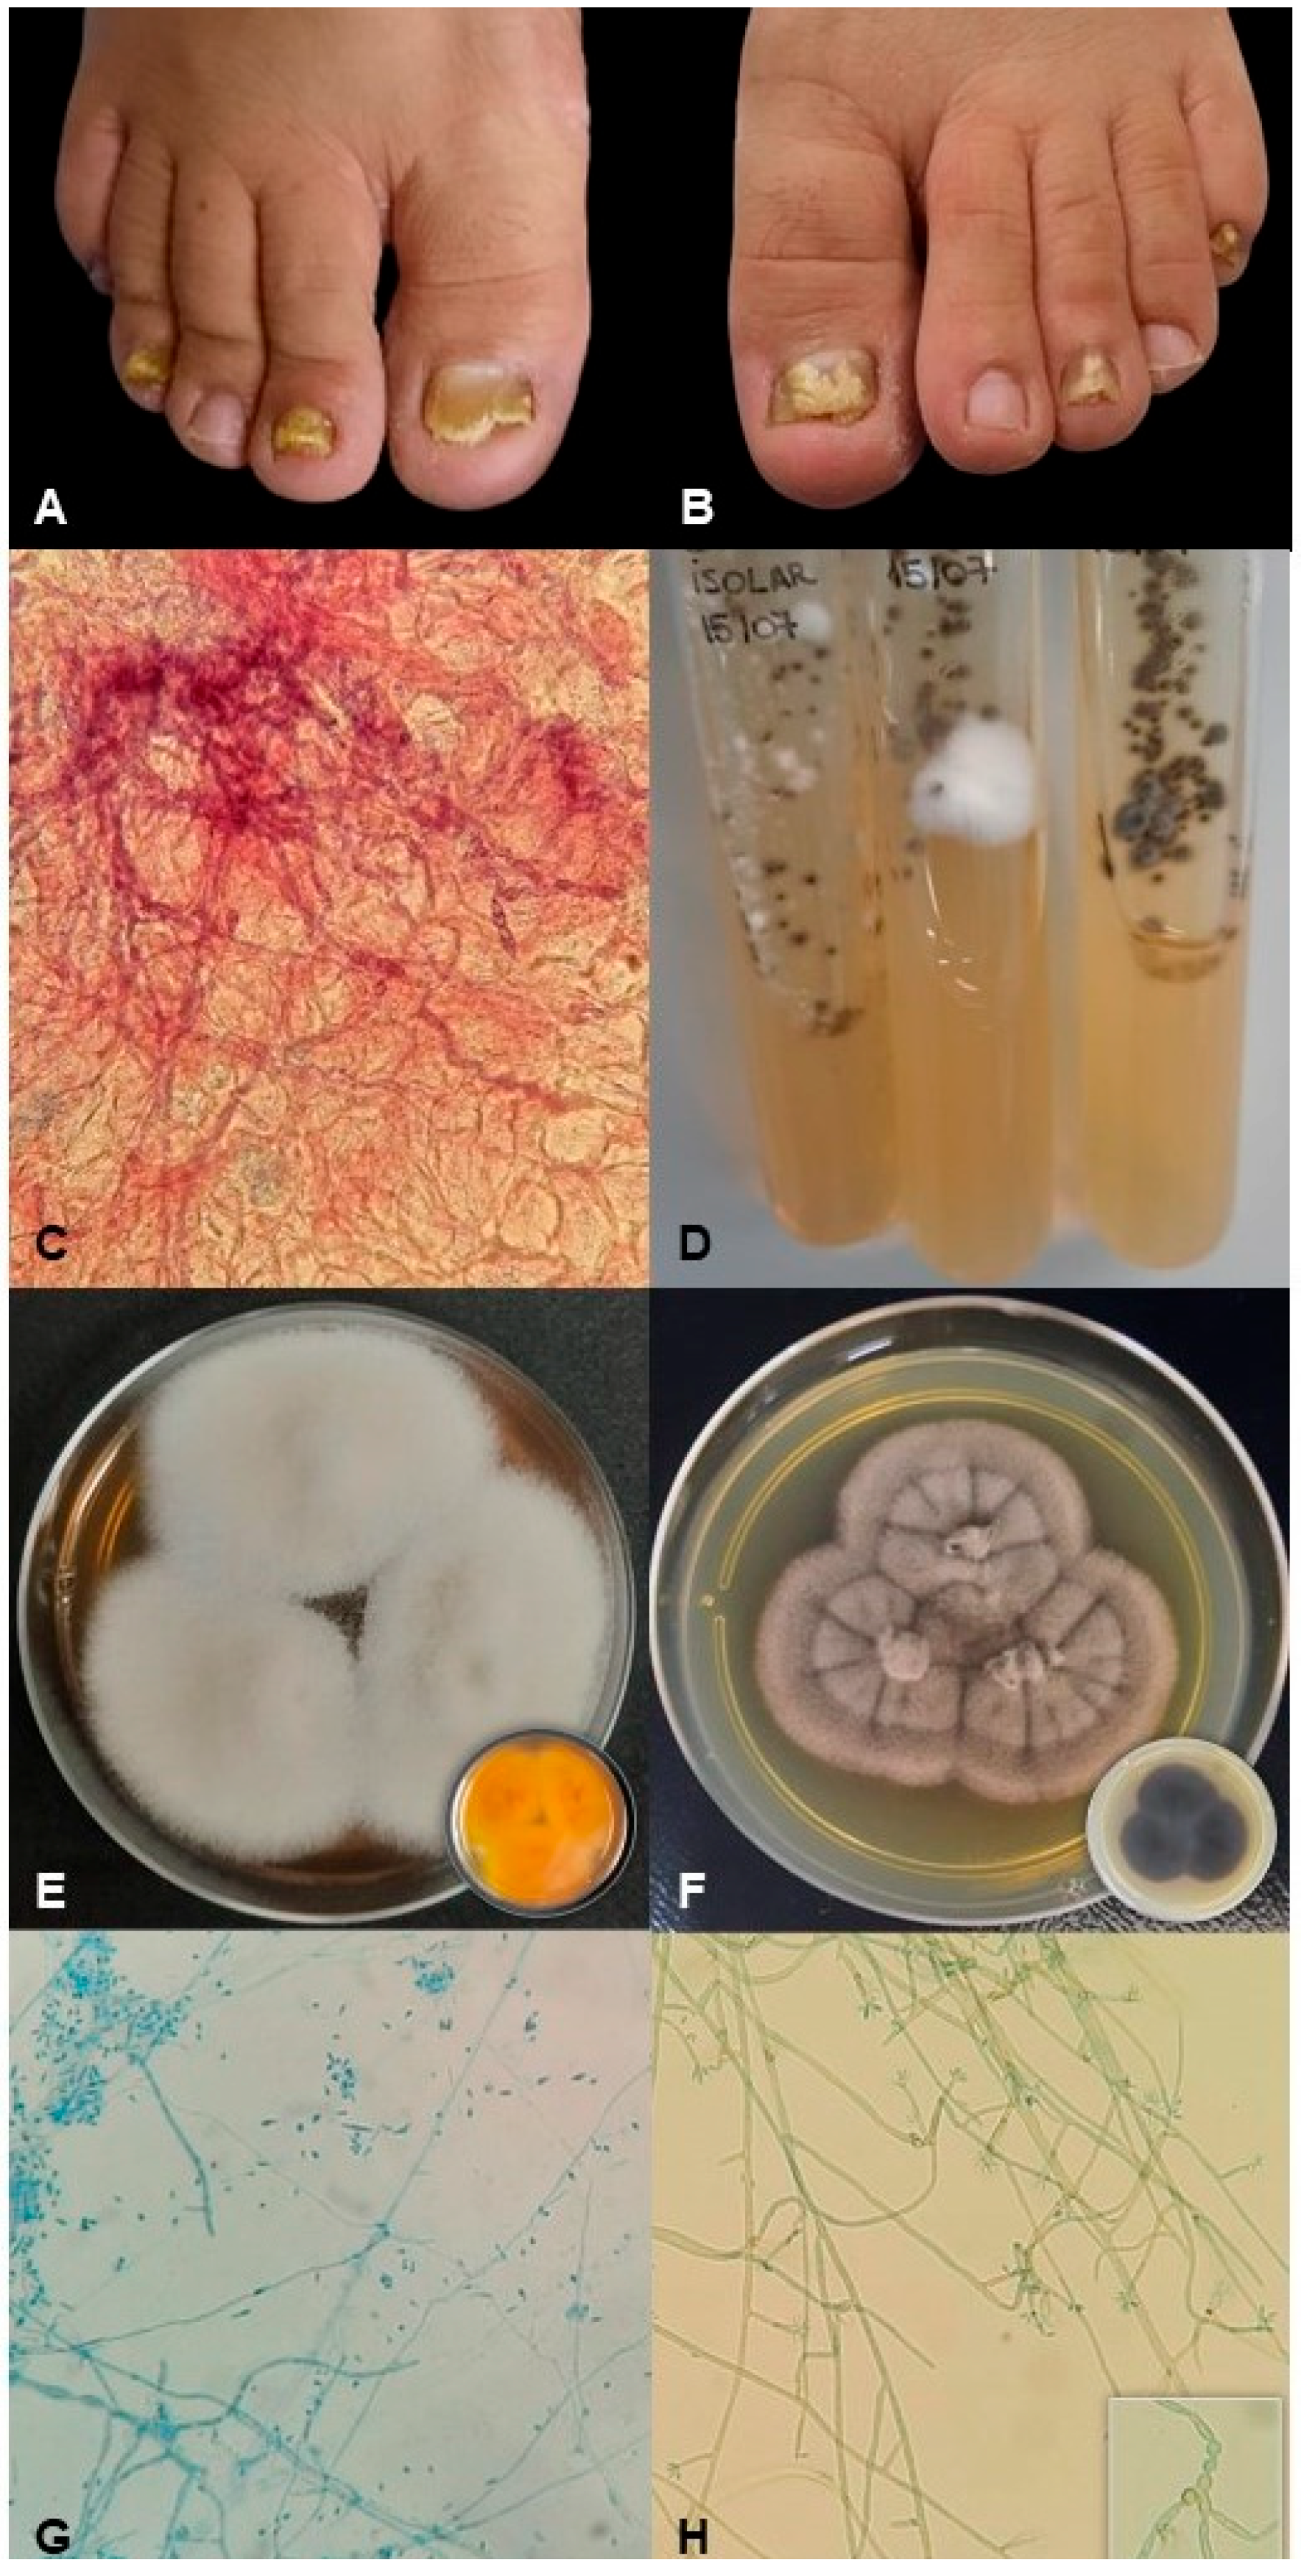
Jof 09 00696 g001
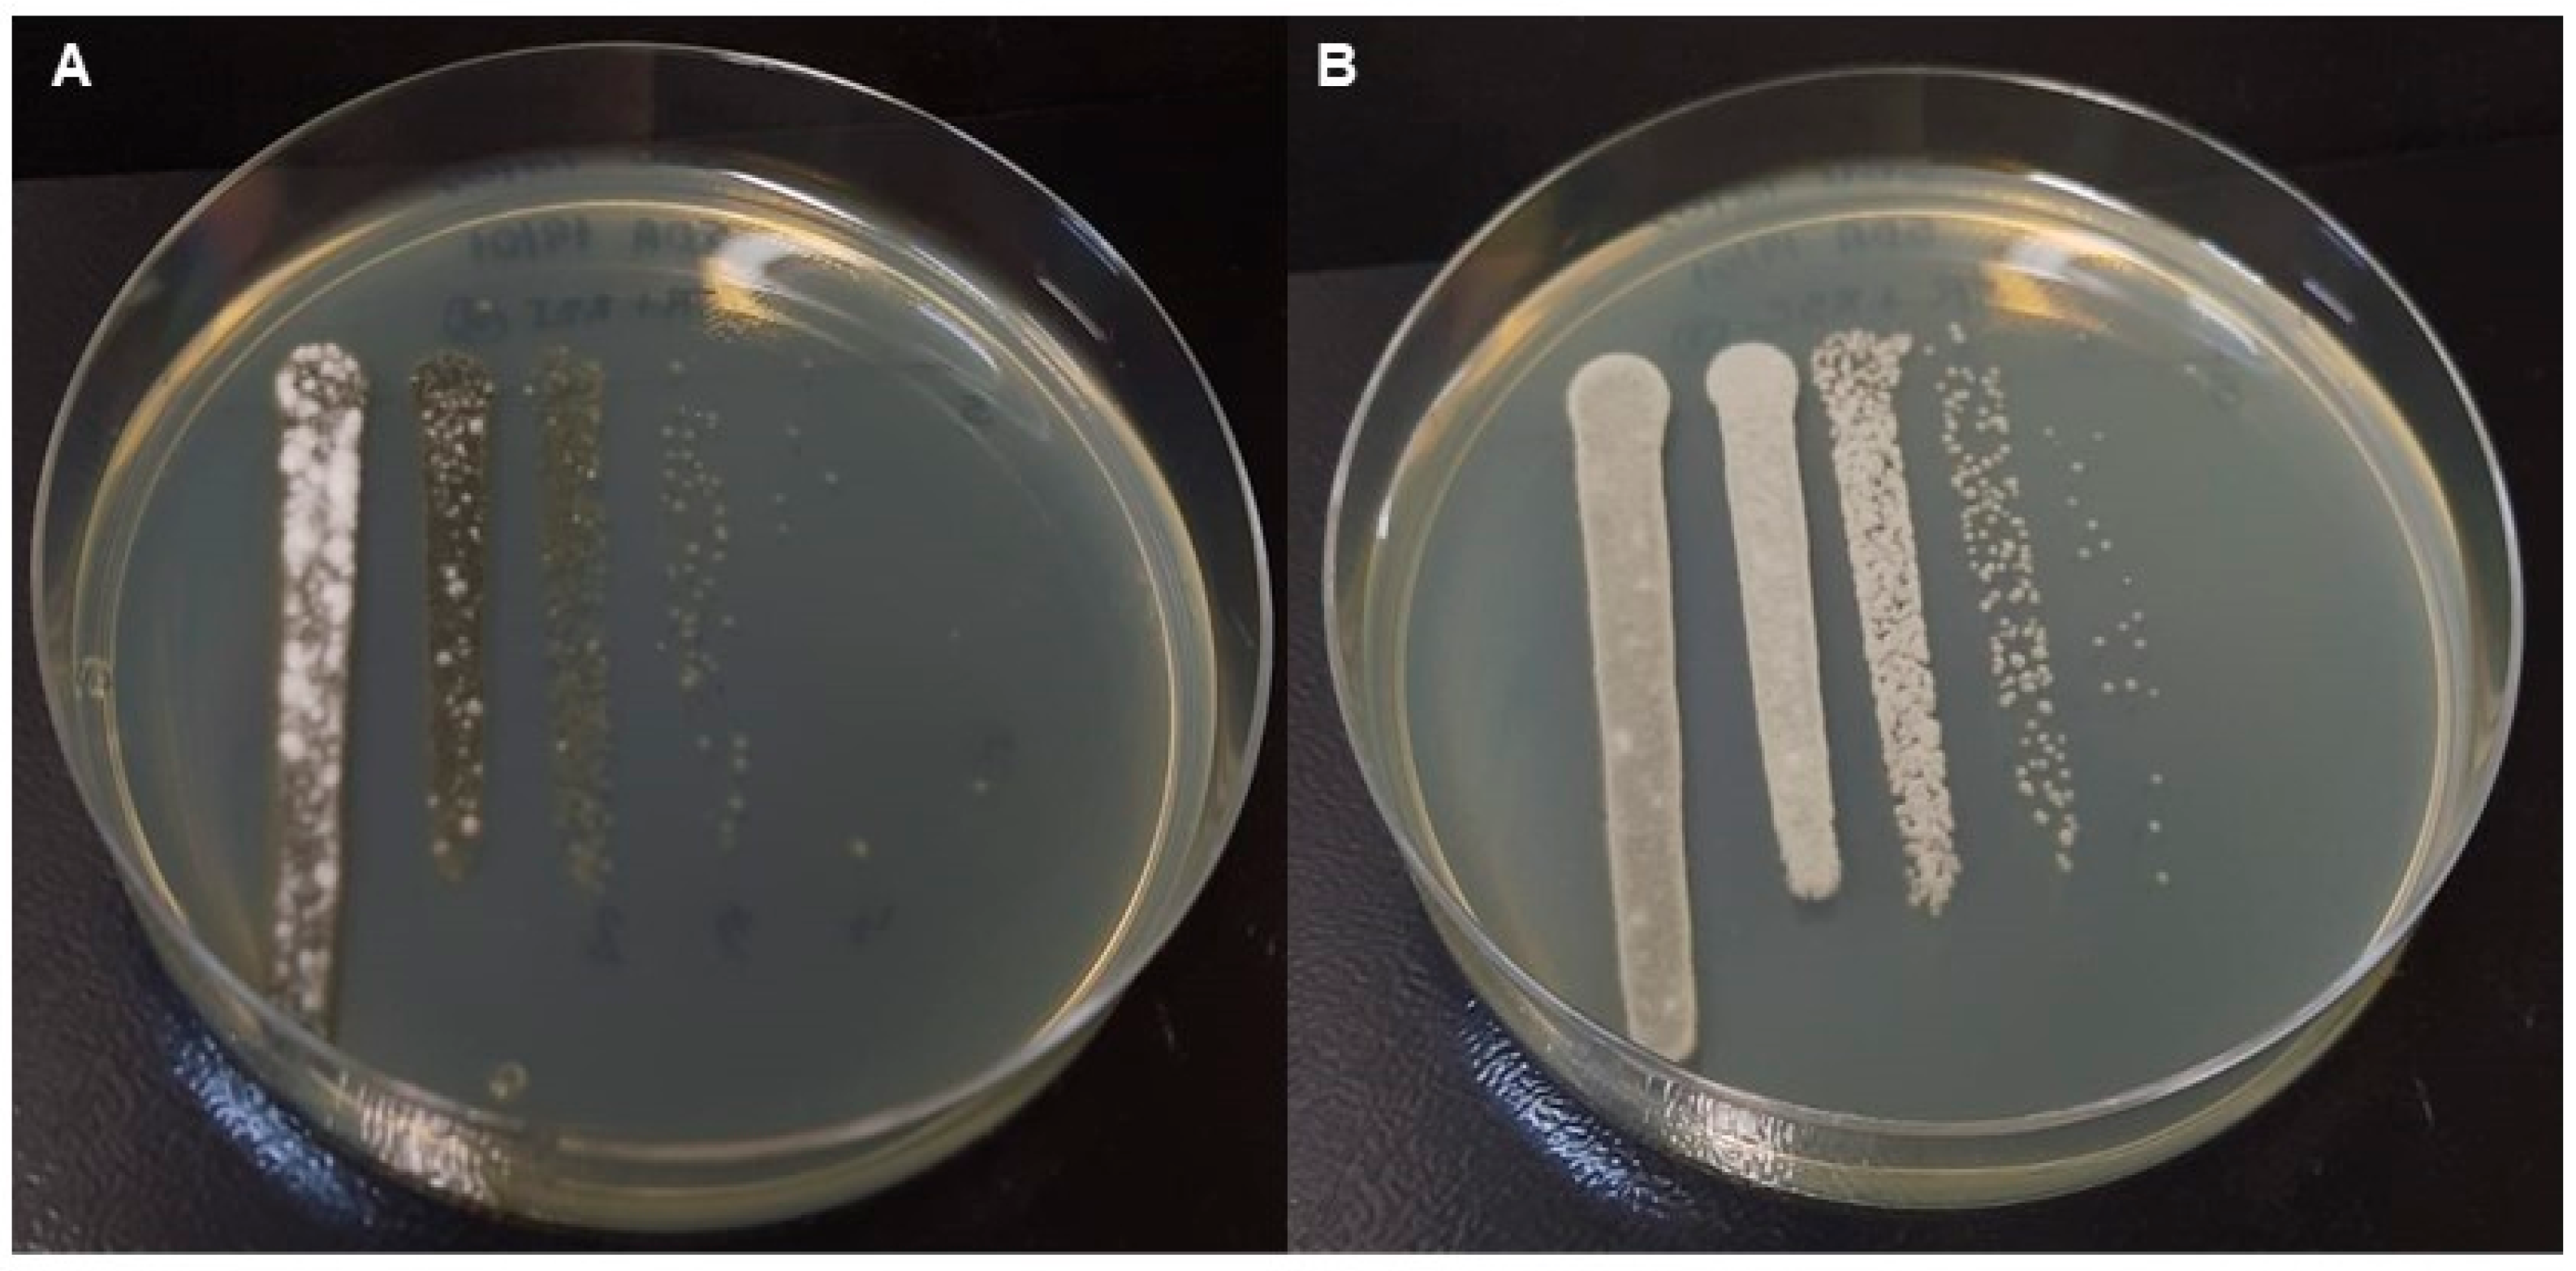
Jof 09 00696 g003

In Vitro and Ex Vivo Biofilm-Forming Ability of Rhinocladiella similis and Trichophyton rubrum Isolated from a Mixed Onychomycosis Case
Abstract
1. Introduction
2. Materials and Methods
2.1. Patient History and Fungal Samples
2.2. Molecular Identification
2.3. The Preparation of Inoculum
2.4. Production of Single and Mixed Fungal Biofilms
Formation of Biofilms on Polystyrene Plate
2.5. Ex Vivo Formation of Biofilms on Healthy Nails
2.6. Number of Cultivable Cells and Metabolic Activity of the Biofilms
2.7. Scanning Electron Microscopy (SEM)
2.8. Statistical Analysis
3. Results
4. Discussion
Author Contributions
Funding
Institutional Review Board Statement
Informed Consent Statement
Data Availability Statement
Conflicts of Interest
References
- Sigurgeirsson, B.; Baran, R. The Prevalence of Onychomycosis in the Global Population: A Literature Study. J. Eur. Acad. Dermatol. Venereol. 2014, 28, 1480–1491. [Google Scholar] [CrossRef] [PubMed]
- Gupta, A.K.; Versteeg, S.G.; Shear, N.H. Onychomycosis in the 21st Century: An Update on Diagnosis, Epidemiology, and Treatment. J. Cutan. Med. Surg. 2017, 21, 525–539. [Google Scholar] [CrossRef] [PubMed]
- Costa, P.S.; Mendes, V.; Veiga, F.F.; Negri, M.; Svidzinski, T.I.E. Relevant Insights into Onychomycosis’ Pathogenesis Related to the Effectiveness Topical Treatment. Microb. Pathog. 2022, 169, 105640. [Google Scholar] [CrossRef] [PubMed]
- Gupta, C.; Das, S.; Gaurav, V.; Singh, P.K.; Rai, G.; Datt, S.; Tigga, R.A.; Pandhi, D.; Bhattacharya, S.N.; Ansari, M.A.; et al. Review on Host-Pathogen Interaction in Dermatophyte Infections. J. Mycol. Med. 2023, 33, 101331. [Google Scholar] [CrossRef]
- Nenoff, P.; Krüger, C.; Ginter-Hanselmayer, G.; Tietz, H.-J. Mycology—An Update. Part 1: Dermatomycoses: Causative Agents, Epidemiology and Pathogenesis. J. Dtsch. Dermatol. Ges. 2014, 12, 188–209. [Google Scholar] [CrossRef]
- Gupta, A.K.; Daigle, D.; Carviel, J.L. The Role of Biofilms in Onychomycosis. J. Am. Acad. Dermatol. 2016, 74, 1241–1246. [Google Scholar] [CrossRef]
- Gupta, A.K.; Taborda, V.B.A.; Taborda, P.R.O.; Shemer, A.; Summerbell, R.C.; Nakrieko, K.-A. High Prevalence of Mixed Infections in Global Onychomycosis. PLoS ONE 2020, 15, e0239648. [Google Scholar] [CrossRef]
- Costa, P.d.S.; Prado, A.; Bagon, N.P.; Negri, M.; Svidzinski, T.I.E. Mixed Fungal Biofilms: From Mycobiota to Devices, a New Challenge on Clinical Practice. Microorganisms 2022, 10, 1721. [Google Scholar] [CrossRef]
- Lima, B.J.F.d.S.; Voidaleski, M.F.; Gomes, R.R.; Fornari, G.; Soares, J.M.B.; Bombassaro, A.; Schneider, G.X.; Soley, B.d.S.; de Azevedo, C.d.M.P.E.S.; Menezes, C.; et al. Selective Isolation of Agents of Chromoblastomycosis from Insect-Associated Environmental Sources. Fungal Biol. 2020, 124, 194–204. [Google Scholar] [CrossRef]
- Gomes, R.R.; Vicente, V.A.; Azevedo, C.M.P.S.; Salgado, C.G.; da Silva, M.B.; Queiroz-Telles, F.; Marques, S.G.; Santos, D.W.C.L.; de Andrade, T.S.; Takagi, E.H.; et al. Molecular Epidemiology of Agents of Human Chromoblastomycosis in Brazil with the Description of Two Novel Species. PLoS Negl. Trop. Dis. 2016, 10, e0005102. [Google Scholar] [CrossRef]
- Heidrich, D.; González, G.M.; Pagani, D.M.; Ramírez-Castrillón, M.; Scroferneker, M.L. Chromoblastomycosis Caused by Rhinocladiella similis: Case Report. Med. Mycol. Case Rep. 2017, 16, 25–27. [Google Scholar] [CrossRef]
- Richarz, N.A.; Jaka, A.; Fernández-Rivas, G.; Bassas, J.; Bielsa, I.; Ferrándiz, C. First Case of Chronic Cutaneous Chromoblastomycosis by Rhinocladiella similis Aquired in Europe. Clin. Exp. Dermatol. 2018, 43, 925–927. [Google Scholar] [CrossRef]
- de Andrade, T.S.; de Almeida, A.M.Z.; Basano, S.A.; Takagi, E.H.; Szeszs, M.W.; Melhem, M.S.C.; Albuquerque, M.; Camargo, J.S.A.A.; Gambale, W.; Camargo, L.M.A. Chromoblastomycosis in the Amazon Region, Brazil, Caused by Fonsecaea pedrosoi, Fonsecaea nubica, and Rhinocladiella similis: Clinicopathology, Susceptibility, and Molecular Identification. Med. Mycol. 2020, 58, 172–180. [Google Scholar] [CrossRef]
- Nucci, M.; Akiti, T.; Barreiros, G.; Silveira, F.; Revankar, S.G.; Sutton, D.A.; Patterson, T.F. Nosocomial Fungemia due to Exophiala Jeanselmei var. Jeanselmei and a Rhinocladiella species: Newly Described Causes of Bloodstream Infection. J. Clin. Microbiol. 2001, 39, 514–518. [Google Scholar] [CrossRef]
- Abdolrasouli, A.; Gibani, M.M.; de Groot, T.; Borman, A.M.; Hoffman, P.; Azadian, B.S.; Mughal, N.; Moore, L.S.P.; Johnson, E.M.; Meis, J.F. A Pseudo-Outbreak of Rhinocladiella similis in a Bronchoscopy Unit of a Tertiary Care Teaching Hospital in London, United Kingdom. Mycoses 2021, 64, 394–404. [Google Scholar] [CrossRef]
- Sun, L.; Wan, Z.; Li, R.; Yu, J. Activities of Nine Antifungal Agents against Rare Pathogenic Fungi. J. Med. Microbiol. 2019, 68, 1664–1670. [Google Scholar] [CrossRef]
- Saunte, D.M.; Tarazooie, B.; Arendrup, M.C.; de Hoog, G.S. Black Yeast-Like Fungi in Skin and Nail: It Probably Matters. Mycoses 2012, 55, 161–167. [Google Scholar] [CrossRef]
- Shi, D.; Lu, G.; Mei, H.; de Hoog, G.S.; Zheng, H.; Liang, G.; Shen, Y.; Li, T.; Liu, W. Onychomycosis Due to with Yellowish Black Discoloration and Periungual Inflammation. Med. Mycol. Case Rep. 2016, 13, 12–16. [Google Scholar] [CrossRef]
- Brasch, J.; Dressel, S.; Müller-Wening, K.; Hügel, R.; von Bremen, D.; de Hoog, G.S. Toenail Infection by Cladophialophora boppii. Med. Mycol. 2011, 49, 190–193. [Google Scholar] [CrossRef]
- Wen, Y.-M.; Rajendran, R.K.; Lin, Y.-F.; Kirschner, R.; Hu, S. Onychomycosis Associated with Exophiala oligosperma in Taiwan. Mycopathologia 2016, 181, 83–88. [Google Scholar] [CrossRef]
- Salvador, A.; Veiga, F.F.; Svidzinski, T.I.E.; Negri, M. Case of Mixed Infection of Toenail Caused by Candida parapsilosis and Exophiala dermatitidis and in Vitro Effectiveness of Propolis Extract on Mixed Biofilm. J. Fungi 2023, 9, 581. [Google Scholar] [CrossRef] [PubMed]
- Alfageme-García, P.; Jiménez-Cano, V.M.; Ramírez-Durán, M.D.V.; Gómez-Luque, A.; Hidalgo-Ruiz, S.; Basilio-Fernández, B. Onychomycosis in Two Populations with Different Socioeconomic Resources in an Urban Nucleus: A Cross-Sectional Study. J. Fungi 2022, 8, 1003. [Google Scholar] [CrossRef] [PubMed]
- Veiga, F.F.; de Castro-Hoshino, L.V.; Sato, F.; Baesso, M.L.; Silva, S.; Negri, M.; Svidzinski, T.I.E. Characterization of a Biofilm Formed by Fusarium oxysporum on the Human Nails. Int. J. Dermatol. 2022, 61, 191–198. [Google Scholar] [CrossRef] [PubMed]
- Antonelli, G.; Cutler, S. Evolution of the Koch Postulates: Towards a 21st-Century Understanding of Microbial Infection. Clin. Microbiol. Infect. 2016, 22, 583–584. [Google Scholar] [CrossRef] [PubMed]
- Idris, N.F.B.; Huang, G.; Jia, Q.; Yuan, L.; Li, Y.; Tu, Z. Mixed Infection of Toe Nail Caused by Trichosporon asahii and Rhodotorula mucilaginosa. Mycopathologia 2020, 185, 373–376. [Google Scholar] [CrossRef]
- Stefanato, C.M.; Verdolini, R. Histopathologic Evidence of the Nondermatophytic Mould Scopulariopsis brevicaulis Masking the Presence of Dermatophytes in a Toenail Infection. J. Cutan. Pathol. 2009, 36 (Suppl. S1), 8–12. [Google Scholar] [CrossRef]
- Lagacé, J.; Cellier, E. A Case Report of a Mixed Chaetomium globosum/Trichophyton mentagrophytes Onychomycosis. Med. Mycol. Case Rep. 2012, 1, 76–78. [Google Scholar] [CrossRef]
- Salakshna, N.; Bunyaratavej, S.; Matthapan, L.; Lertrujiwanit, K.; Leeyaphan, C. A Cohort Study of Risk Factors, Clinical Presentations, and Outcomes for Dermatophyte, Nondermatophyte, and Mixed Toenail Infections. J. Am. Acad. Dermatol. 2018, 79, 1145–1146. [Google Scholar] [CrossRef]
- Veiga, F.F.; de Castro-Hoshino, L.V.; Rezende, P.S.T.; Baesso, M.L.; Svidzinski, T.I.E. Insights on the Etiopathogenesis of Onychomycosis by Dermatophyte, Yeast and Non-Dermatophyte Mould in Ex Vivo Model. Exp. Dermatol. 2022, 31, 1810–1814. [Google Scholar] [CrossRef]
- Anversa, L.; Lara, B.R.; Romani, C.D.; Saeki, E.K.; Nogueira Nascentes, G.A.; Bonfietti, L.X.; Melhem, M.S.C.; da Silva Ruiz, L.; Camargo, C.H.; Pereira, V.B.R. Fungi in Dialysis Water and Dialysate: Occurrence, Susceptibility to Antifungal Agents and Biofilm Production Capacity. J. Water Health 2021, 19, 724–735. [Google Scholar] [CrossRef]
- Garcia, L.M.; Costa-Orlandi, C.B.; Bila, N.M.; Vaso, C.O.; Gonçalves, L.N.C.; Fusco-Almeida, A.M.; Mendes-Giannini, M.J.S. A Two-Way Road: Antagonistic Interaction between Dual-Species Biofilms Formed by Candida albicans/Candida parapsilosis and Trichophyton rubrum. Front. Microbiol. 2020, 11, 1980. [Google Scholar] [CrossRef]
- Grumbt, M.; Monod, M.; Yamada, T.; Hertweck, C.; Kunert, J.; Staib, P. Keratin Degradation by Dermatophytes Relies on Cysteine Dioxygenase and a Sulfite Efflux Pump. J. Investig. Dermatol. 2013, 133, 1550–1555. [Google Scholar] [CrossRef]
- Galletti, J.; Negri, M.; Grassi, F.L.; Kioshima-Cotica, É.S.; Svidzinski, T.I.E. Fusarium spp. Is Able to Grow and Invade Healthy Human Nails as a Single Source of Nutrients. Eur. J. Clin. Microbiol. Infect. Dis. 2015, 34, 1767–1772. [Google Scholar] [CrossRef]
- Burmester, A.; Shelest, E.; Glöckner, G.; Heddergott, C.; Schindler, S.; Staib, P.; Heidel, A.; Felder, M.; Petzold, A.; Szafranski, K.; et al. Comparative and Functional Genomics Provide Insights into the Pathogenicity of Dermatophytic Fungi. Genome Biol. 2011, 12, R7. [Google Scholar] [CrossRef]
- Ciesielska, A.; Kawa, A.; Kanarek, K.; Soboń, A.; Szewczyk, R. Metabolomic Analysis of Trichophyton rubrum and Microsporum canis during Keratin Degradation. Sci. Rep. 2021, 11, 3959. [Google Scholar] [CrossRef]
- Ruiz, A.; Herráez, M.; Costa-Gutierrez, S.B.; Molina-Henares, M.A.; Martínez, M.J.; Espinosa-Urgel, M.; Barriuso, J. The Architecture of a Mixed Fungal-Bacterial Biofilm Is Modulated by Quorum-Sensing Signals. Environ. Microbiol. 2021, 23, 2433–2447. [Google Scholar] [CrossRef]

Disclaimer/Publisher’s Note: The statements, opinions and data contained in all publications are solely those of the individual author(s) and contributor(s) and not of MDPI and/or the editor(s). MDPI and/or the editor(s) disclaim responsibility for any injury to people or property resulting from any ideas, methods, instructions or products referred to in the content. |
© 2023 by the authors. Licensee MDPI, Basel, Switzerland. This article is an open access article distributed under the terms and conditions of the Creative Commons Attribution (CC BY) license (https://creativecommons.org/licenses/by/4.0/).
Share and Cite
Costa, P.d.S.; Basso, M.E.; Negri, M.; Svidzinski, T.I.E. In Vitro and Ex Vivo Biofilm-Forming Ability of Rhinocladiella similis and Trichophyton rubrum Isolated from a Mixed Onychomycosis Case. J. Fungi 2023, 9, 696. https://doi.org/10.3390/jof9070696
Costa PdS, Basso ME, Negri M, Svidzinski TIE. In Vitro and Ex Vivo Biofilm-Forming Ability of Rhinocladiella similis and Trichophyton rubrum Isolated from a Mixed Onychomycosis Case. Journal of Fungi. 2023; 9(7):696. https://doi.org/10.3390/jof9070696
Chicago/Turabian StyleCosta, Polyana de Souza, Maria Eduarda Basso, Melyssa Negri, and Terezinha Inez Estivalet Svidzinski. 2023. "In Vitro and Ex Vivo Biofilm-Forming Ability of Rhinocladiella similis and Trichophyton rubrum Isolated from a Mixed Onychomycosis Case" Journal of Fungi 9, no. 7: 696. https://doi.org/10.3390/jof9070696
APA StyleCosta, P. d. S., Basso, M. E., Negri, M., & Svidzinski, T. I. E. (2023). In Vitro and Ex Vivo Biofilm-Forming Ability of Rhinocladiella similis and Trichophyton rubrum Isolated from a Mixed Onychomycosis Case. Journal of Fungi, 9(7), 696. https://doi.org/10.3390/jof9070696

